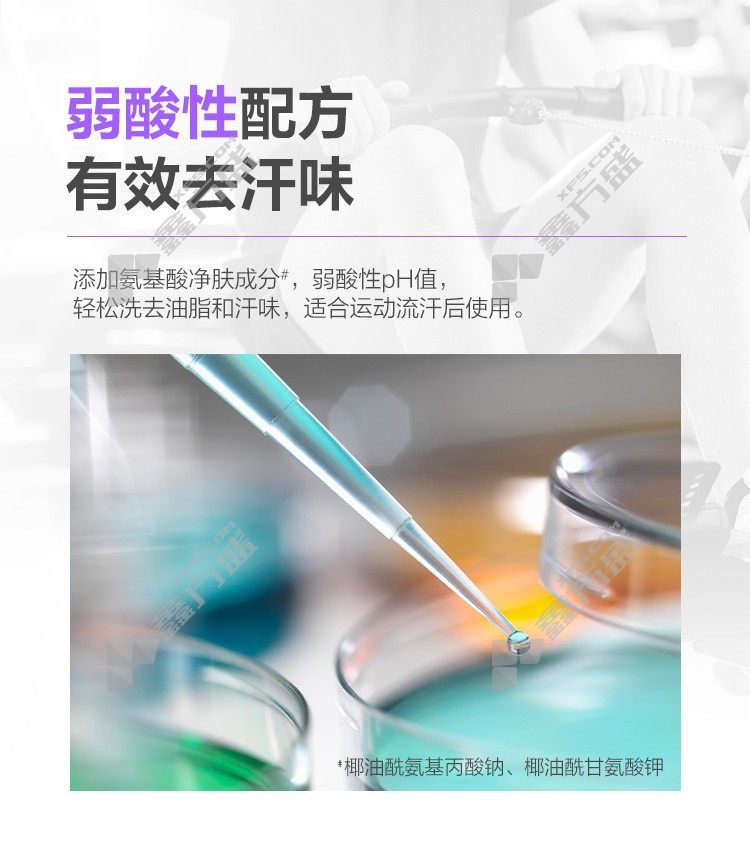

super power supnice men's sports essential oil fragrance shower gel (vitality and freshness )260ml (ocean cool )600ml
Full-court postage
7 days no reason to return.
Quick refund
shopping cart
add to cart
Graphic details
comment(0)